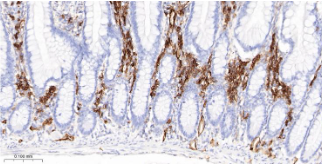

Human CD38 Ready-To-Use IHC Kit
Human CD38 Ready-To-Use IHC Kit
Cat. No.: IHC0228HSample Type: FFPE tissue
Size: 50T (including a control slide)
Storage and Stability: Please store components at the temperatures indicated on the individual tube labels. The kit is stable for 6 months from the date of receipt.
Background
CD38 (NAD+ glycohydrolase) is a type II transmembrane glycoprotein able to induce activation, proliferation and differentiation of mature lymphocytes and mediate apoptosis of myeloid and lymphoid progenitor cells. CD38 functions as a multi-catalytic ectoenzyme serving as ADP-ribosyl cyclase, cyclic ADP-ribose hydrolase and possibly NAD+ glycohydrolase or as a cell surface receptor. Antibodies to CD38 are useful in subtyping of lymphomas and leukemias, detection of plasma cells (i.e. identification of myelomas), and as a marker for activated B and T cells. CD38 participates in cell adhesion, signal transduction and calcium signaling. Further, CD38 is expressed at high levels in the pancreas, liver, kidney, malignant lymphoma and neuroblastoma. Diseases associated with CD38 dysfunction include chronic lymphocytic leukemia and Richter's Syndrome.
Synonyms
Cd38; Cd38-rs1; ADP-ribosyl cyclase/cyclic ADP-ribose hydrolase 1; 2-phospho-ADP-ribosyl cyclase; 2-phospho-ADP-ribosyl cyclase/2-phospho-cyclic-ADP-ribose transferase; 2-phospho-cyclic-ADP-ribose transferase; ADP-ribosyl cyclase 1; ADPRC 1; Cyclic ADP-ribose hydrolase 1; cADPr hydrolase 1; T10; CD38_HUMAN.Validation Data
Materials Supplied
| Number | Component | 50T | Concentration | Storage |
|---|---|---|---|---|
| 1 | PBS Buffer (powder) | 2L x 2 | 20x | RT |
| 2 | Antigen Retrieval Buffer | 20ml | 100x | 2-8°C |
| 3 | Endogenous Peroxidase Blocking Buffer | 3ml | RTU | 2-8°C |
| 4 | Blocking Buffer | 3ml | RTU | 2-8°C |
| 5 | Primary Antibody (Human CD38 Mouse mAb) | 6ml | RTU | 2-8°C |
| 6 | "Secondary Antibody (AffiniPure Goat Anti-Mouse IgG H&L, HRP conjugated) | "6ml | RTU | 2-8°C |
| 7 | Chromogen Component A | 0.3ml | RTU | -20°C |
| 8 | Chromogen Component B | 0.3ml | RTU | -20°C |
| 9 | Counter Staining Reagent | 5ml | RTU | RT |
| 10 | Differentiation Reagent | 6ml | RTU | RT |
| 11 | Mounting Media | 5ml | RTU | RT |
| 12 | Control slide (Human tonsil) | 1 slide | RTU | RT |
| 13 | Datasheet | 1 copy |
Notes
- The positive control slide provided in the kit allows you to be sure that the experimental set-up is working properly.
- Do not allow slides to dry at any time during this procedure.
- Please don't replace the matching reagents in this product with other manufacturers' products.
- As DAB is a carcinogen, please take necessary precautions.
- PBS (reagent 1) can be stored for one week at 4℃ after preparation; The antigen retrieval buffer (1×reagent 2) and the chromogenic agent (the mixture of reagents 7 and 8) should be prepared right before each assay.
As DAB is a carcinogen, please take necessary precautions.
Important Note: This product as supplied is intended for research use only, not for use in human, therapeutic or diagnostic applications.